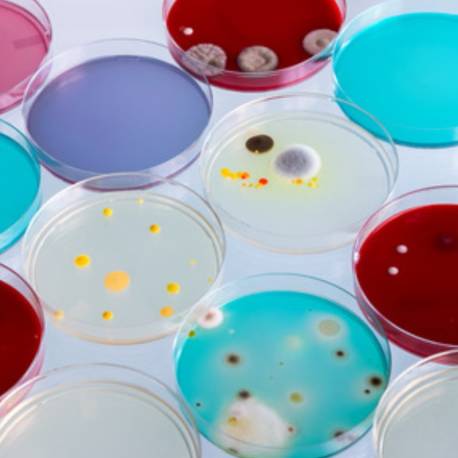
Pack de 3 placas Petri de plástico  Física y Experimentos

Transforma tu carrito en una lista de deseos, y compártela con quien quieras.
Regístrate y haz clic en el corazón de cada producto de tu cesta
Física y Experimentos
Gafas de experimentos para niños
Añadir a mi lista de deseos "Gafas de experimentos para niños"
Selecciona una lista
No hay listas de deseos.
Este producto ha sido añadido a la lista de deseos.
Ver mis listas de deseo
Crear una nueva lista
Este producto ha sido añadido a la lista de deseos.
Ver mis listas de deseo
Sugerencias
Este producto ha sido añadido a la lista de deseos.
Eliminar
Este producto fue eliminado correctamente de tus listas de deseos.
Física y Experimentos
Rack 14 tubos de muestras
Añadir a mi lista de deseos "Rack 14 tubos de muestras"
Selecciona una lista
No hay listas de deseos.
Este producto ha sido añadido a la lista de deseos.
Ver mis listas de deseo
Crear una nueva lista
Este producto ha sido añadido a la lista de deseos.
Ver mis listas de deseo
Sugerencias
Este producto ha sido añadido a la lista de deseos.
Eliminar
Este producto fue eliminado correctamente de tus listas de deseos.

.jpg)